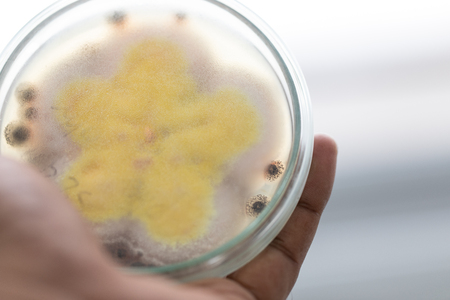

写真素材 - Mold Beautiful, Colony of Characteristics of Fungus (Mold) in culture medium plate from laboratory microbiology.
作品情報
Mold Beautiful, Colony of Characteristics of Fungus (Mold) in culture medium plate from laboratory microbiology.
- ID:109208512
- 作品種別:写真
- 作者名:sinhyu
キーワード
- Rhizomes
- abstract
- allergy
- antibiotic
- ascomycetous
- aspergillus
- background
- bacteria
- biological
- biology
- black
- bread
- cells
- closeup
- colony
- conidiospores
- corrosion
- culture
- detail
- disease
- drug
- education
- food
- fungal
- fungi
- fungus
- green
- growth
- health
- healthcare
- hygiene
- hyphae
- infection
- infectious
- isolated
- lab
- laboratory
- life
- macro
- medicine
- micro
- microbe
- microbes
- microbial
- microbiology
- microscope
- microscopic
- mildew
- mold
- moldy
- mould
- mycelium
- mycology
- mycosis
- organic
- pencil-like
- penicillium
- petri
- plate
- research
- rotten
- rotting
- round
- science
- scientific
- spoiled
- spore
- spores
- test
- texture
- white
- yeast
類似作品
Mold and fungus...
fungus on rot f...
Mold and fungus...
Mold and fungus...
Mold and fungus...
Mold Beautiful,...
Mold and fungus...
Wasps are aggre...
Old moss on the...
Pumpkin covered...
Overgrown green...
Mold on food Fr...
Beach of Etreta...
This microscopi...
Mold and fungus...
Black mold on w...
Mold and fungus...
Natural texture...
Black mold buil...
Close up view o...
A dense forest ...
Pumpkin covered...
Frozen green gr...
full frame yell...
Variety of natu...
Beautiful Brigh...
close-up of a w...
close-up of a f...
Mold and fungus...
Termites are in...
Rust spots on a...
Dying variable ...
Mold on the foo...
Mold in the ref...
black mealworms...
close up of fun...
Abstract hexago...
Bubbles on a wo...
Thyme while bei...
Moss stalks Bry...
Macro detail of...
white soap foam...
Bees in a beehi...
View of the nat...
Characteristics...
Extreme close-u...
the detail of t...
Detail of the f...